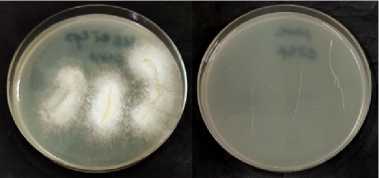
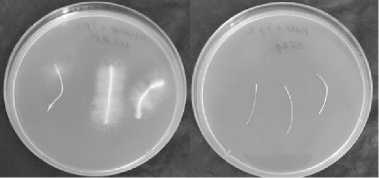

Колонизация корней и стимуляция роста сельскохозяйственных растений аскомицетом Trichoderma asperellum
Автор: Дубровская Е.В., Позднякова Н.Н., Давлетбаев И.М., Муратова А.Ю.
Журнал: Сельскохозяйственная биология @agrobiology
Рубрика: Стимуляция роста растений
Статья в выпуске: 1 т.61, 2026 года.
Бесплатный доступ
Аскомицеты рода Trichoderma широко распространены в почвенных микробиомах и способны вступать в сложные и разнообразные взаимоотношения с различными почвенными организмами, в том числе с растениями. Гриб Trichoderma asperellum используется в качестве агента биоконтроля для улучшения роста растений и служит основой многих биофунгицидных препаратов. Однако, принимая во внимание неоднозначность взаимодействия Trichoderma с растениями, необходимы прицельные исследования и широкое тестирование отобранных перспективных штаммов с использованием различных видов растений. В настоящей работе впервые проведена комплексная оценка эффективности инокуляции грибом Trichoderma asperellum широкого круга сельскохозяйственных растений по накоплению биомассы и колонизации корней в стерильных условиях in vitro и в почве. Целью работы была оценка колонизации корней и определение ростостимулирующего эффекта инокуляции сельскохозяйственных растений коммерческим штаммом Trichodermaasperellum. Работу проводили в Институте биохимии и физиологии растений и микроорганизмов, ФИЦ Саратовский научный центр РАН (ИБФРМ РАН) с мая по август 2024 года. Использовали коммерческий штамм T. asperellum OPF-19 (ВКПМ F-1323) и семена рапса Brassica napus L. сорта Визит, сои Glycine max (L.) Merr. сорта Бара, кукурузы Zea mays L. (гибрид РНИИСХ-19), подсолнечника Helianthus annuus L. сорта Саратовский 20, пшеницы яровой Triticum aestivum L. сорта Саратовская 74. Для инокуляции растений T. asperellum получали споры гриба, выращивая его на агаризованной среде BRM в течение 5 сут. Семена растений стерилизовали поверхностно гипохлоритом натрия, раскладывали на поверхность разбавленного (1:1) агара ГРМ и выдерживали в термостате при 29 °С в течение 2-3-сут для контроля стерильности. Для пшеницы использовали глубокую стерилизацию семян диацидом. Процесс колонизации корней грибом T. asperellum изучали, выращивая инокулированные и неинокулированные стерильные растения в агаризованной (0,4 %) минеральной среде Кнопа. Для выявления гриба и определения его локализации на поверхность агаризованной среды BRM раскладывали отрезки опытных нативных и поверхностно стерилизованных этанолом и гипохлоритом корней, полученные из различных зон: роста, всасывания и проведения (боковых корней). Чашки с корнями инкубировали при 29 °С в течение 2 сут, затем отмечали участки корней, в которых выявлялся рост гриба. Дополнительно эффективность колонизации определяли микроскопированием корней в проходящем свете (микроскоп Leica DM2500, «Leica Microsystems GmbH», Германия). Гифы и споры T. asperellum предварительно окрашивали трипановым синим. Эффект инокуляции оценивали по длине побегов и корней растений, в случае стержневой корневой системы определяли длину главного корня, в случае мочковатой — их суммарную длину. Для почвенных экспериментов использовали чернозем южный. В вегетационные сосуды помещали по 1 кг почвы, увлажняли ее до 50 % от полной влагоемкости. В каждый сосуд высевали по 20 семян, после всходов оставляли по 10 проростков. Через 14 сут после посева в горшки вносили споры гриба в количестве 107 клеток/г почвы. Повторную инокуляцию проводили через 1 мес после первой. Продолжительность вегетационного опыта составляла 2 мес. Установлено, что гриб колонизировал поверхность корней всех исследованных растений, не проникая внутрь, выявлялся вегетативный мицелий и конидии. У подсолнечника в 4 раза уменьшалась длина побега и почти в 7 раз — корня, у рапса и сои — примерно на 20 и 50 %, у злаков побеги развивались так же, как и у контрольных растений, а длина корневой системы уменьшалась на 50 и 20 % у кукурузы и пшеницы, соответственно. В почвенном эксперименте с нестерильными растениями инокуляция оказывала положительный эффект на накопление и надземной, и подземной биомассы у рапса (соответственно +26 и 39 %) и подсолнечника (+14 и 17 %). У растений сои присутствие T. asperellum стимулировало развитие лишь корневой системы (+ 40 %), тогда как надземная часть практически не отличалась от контроля. В отношении злаковых обнаруживался выраженный негативный эффект инокуляции: накопление надземной биомассы снижалось на 11 и 24 %, подземной биомассы — на 32 и 64 % соответственно для кукурузы и пшеницы. Полученные результаты свидетельствуют о влиянии условий культивирования на проявление эффекта инокуляции грибом и, как следствие, о необходимости тщательного подбора условий тестирования штаммов, перспективных для стимуляции роста сельскохозяйственных культур.
Trichoderma asperellum, Brássica nápus L., рапс, Glycine max (L.) Merr., соя, Zea mays L., кукуруза, Helianthus annuus L., подсолнечник, Triticum aestivum L., пшеница яровая, стимуляция роста растений, биоконтроль
Короткий адрес: https://sciup.org/142247335
IDR: 142247335 | УДК: 579.64:631.46 | DOI: 10.15389/agrobiology.2026.1.132rus
Roots colonization and growth promotion of agricultural plant species by the ascomycete Trichoderma asperellum
Ascomycetes of the Trichoderma genus are widespread in soil microbiomes and can form complex and diverse relationships with various soil organisms, including plants. The fungus Trichoderma asperellum is used as a biocontrol agent to improve plant growth and serves as the basis for many biofungicides. However, given the ambiguity of Trichoderma interactions with plants, targeted research and extensive testing of selected promising strains across various plant species are necessary. Comprehensively assessment of the effectiveness of Trichoderma asperellum inoculation of a wide range of agricultural plants in terms of biomass accumulation and root colonization under sterile conditions in vitro and in soil was conducted for the first time in this study. The objective of this study was to evaluate root colonization and determine the growth-promoting effect of inoculation of agricultural plants with a commercial strain of Trichoderma asperellum. The work was carried out at the Institute of Biochemistry and Physiology of Plants and Microorganisms, Saratov Scientific Centre RAS (IBPPM RAS) from May to August, 2024. The commercial strain T. asperellum OPF-19 (VKPM F-1323) and seeds of rape Brássica nápus L. variety Visit, soybean Glycine max (L.) Merr. variety Bara, corn Zea mays L. (hybrid RNIISKh-19), sunflower Helianthus annuus L. variety Saratovsky 20, spring wheat Triticum aestivum L. variety Saratovskaya 74 were used in this study. To inoculate plants with T. asperellum, fungal spores were obtained by growing fungus on BRM agar medium for 5 days. Plant seeds were surface-sterilized with sodium hypochlorite, placed on the surface of diluted (1:1) BRM agar, and incubated at 29 °С for 2-3 days to control sterility. For wheat, deep sterilization of seeds with diacid was used. The process of root colonization by the fungus T. asperellum was studied by growing inoculated and non-inoculated sterile plants in Knop mineral agar (0.4 %) medium. To detect and determine localization of the fungus, experimental native and surface-sterilized with ethanol and hypochlorite root sections obtained from different root areas (growth zone, absorption zone, and conduction (lateral roots) zone) were placed on the surface of the BRM agar medium. The dishes with roots were incubated at 29 °С for 2 days, and then the root areas in which fungal growth was detected were noted. Additionally, colonization efficiency was determined by observing the roots in transmitted light using a Leica DM2500 microscope (Leica Microsystems GmbH, Germany). T. asperellum hyphae and spores were pre-stained with trypan blue. The inoculation effect was assessed by the length of plant shoots and roots. In the case of a taproot system, the length of the main root was determined, while in the case of a fibrous root system, their combined length was determined. Southern chernozem was used for soil experiments. One kilogram of soil was packed in vegetation pots and moistened to 50% of the total moisture capacity. Twenty seeds were sown in each pot, and 10 seedlings were left in each pot after germination. Fourteen days after sowing, fungal spores were added to the pots at a rate of 107 cells per gram of soil. Repeated inoculation was carried out one month after the first. The duration of the vegetation experiment was two months. The fungus was found to colonize the root surface of all studied plants without penetrating the roots; vegetative mycelium and conidia were detected. In sunflower, shoot length decreased by 4 times and root length by almost 7 times; in rapeseed and soybean, by approximately 20 and 50 %, respectively. In cereals, shoot development was similar to that of control plants, while root system length decreased by 50 and 20 % in corn and wheat, respectively. In a soil experiment with non-sterile plants, inoculation had a positive effect on the accumulation of both aboveground and belowground biomass in rapeseed (+26 % and 39 %, respectively) and sunflower (+14 % and 17 %). In soybean plants, the presence of T. asperellum stimulated the development of the root system (+40 %) only, while the aboveground part was virtually indistinguishable from the control. A significant negative effect of inoculation was observed in cereals: aboveground biomass accumulation decreased by 11 and 24 %, while belowground biomass decreased by 32 and 64 % for corn and wheat, respectively. These results demonstrate the influence of cultivation conditions on the manifestation of the fungal inoculation effect, and, in consequence, the need for careful selection of testing conditions for strains promising for growth stimulation of agricultural crops.
Текст научной статьи Колонизация корней и стимуляция роста сельскохозяйственных растений аскомицетом Trichoderma asperellum
Аскомицеты рода Trichoderma — один из доминирующих компонентов почвенных микробиомов, в том числе ризосферных (1). Эти грибы способны колонизировать корни растений, образуя сложные связи как с хозяином, так и с другими членами микробного сообщества. Стратегии взаимодействия Trichoderma с различными организмами включают антибиоз, колонизацию, конкуренцию за питательные вещества и пространство, изменение условий окружающей среды, прямой микопаразитизм, разрушение клеточных стенок патогенов, индукцию у растений защитной реакции против патогенов (1-4). Кроме того, многие виды Trichoderma действуют как стимуляторы роста растений, или биоудобрения, посредством синтеза и высвобождения фитогормонов (ауксинов, цитокининов, гиббереллинов, салициловой и абсцизовой кислот), фермента 1-аминоциклопропан-1-карбокси-латдезаминазы, растворения питательных веществ, присутствующих в почве (таких как фосфор и калий), или выработки сидерофоров для хелатирования металлов (таких как железо, медь, цинк или магний) (5, 6). Trichoderma индуцирует системную устойчивость растения и толерантность к таким абиотическим стрессам, как засуха и соленость, за счет усиления роста корней (7), увеличения эффективности фотосинтеза (8), усвоения питательных веществ и защиты от окислительного стресса (6, 9, 10). Такое разнообразие механизмов благоприятного воздействия на рост растений вызывает интерес к этим грибам, что привело к широкому использованию Trichoderma в сельском хозяйстве. Около 60 % всех основанных на грибах препаратов биоконтроля составляют биопестициды на основе Trichoderma (2, 11-15).
Устанавливая мутуалистические отношения с растениями, Trichoderma вызывает ряд сложных сигнальных событий, которые в конечном итоге способствуют росту и повышают устойчивость к биотическим и абиотическим стрессам (16). Взаимодействие Trichoderma с растениями опосредуют механизмы, основанные на секреции эффекторных молекул и вторичных метаболитов (17). Триходерма синтезирует молекулы, такие как богатые цистеином гидрофобины, распознаваемые рецепторами корневых клеток, а растение выделяет с корневыми экссудатами углеводы, липиды, терпеноиды и аминокислоты, которые распознаются триходермой, направляя ее рост (18). Достигая корней, гифы Trichoderma вступают с ними в контакт и проникают внутрь через каналы, образованные посредством разрушения стенок растительных клеток с помощью различных целлюлолитических ферментов (16). Попав внутрь корня, Trichoderma колонизирует клеточный апопласт. Однако колонизация ограничивается только поверхностью, эпидермисом и внешними слоями коры корня, не достигая внутренних слоев коры или сосудистых пучков (2). На протяжении всего симбиоза Trichoderma -растение устанавливается молекулярный диалог, в котором рецепторы растительных клеток распознают молекулярные паттерны Trichoderma (стерины, хитин и в -глюканы) в апопласте, вызывая локальные и системные сигналы в растении-хозяине (2).
Однако стимуляция роста растений не является универсальной чертой всех триходерм. В ряде случаев может наблюдаться полное отсутствие положительного эффекта или негативное воздействие грибов Trichoderma даже в пределах одного вида. Например, T. asperellum — один из широко используемых видов в качестве агента биоконтроля для улучшения роста растений (19) — может индуцировать у растений и патогенез (20). T. virens синтезирует ингибиторы роста растений, такие как виридиол — мощное гербицидное соединение, которое эффективно для борьбы с сорняками (21). Синтезируемый в совместной культуре T. harzianum и Catharanthus roseus трихозетин способен подавлять рост корней и побегов у ряда растений, повреждая клеточную мембрану (22). Поверхностная колонизация корня, из-за которой растение не может усваивать питательные вещества и/или воду или даже прямая мацерация тканей корня под действием специфических синтезируемых грибом соединений могут быть причинами летального воздействия Trichoderma на растения (2).
Принимая во внимание разноплановость взаимодействия Trichoderma с растениями и неоднозначность взаимных реакций, необходимы прицельные исследования и широкое тестирование отобранных перспективных штаммов с использованием различных видов растений.
В настоящей работе впервые проведена комплексная оценка эффективности инокуляции грибом Trichoderma asperellum широкого круга сельскохозяйственных растений по накоплению биомассы и колонизации корней в стерильных условиях in vitro и в почве.
Целью исследования была оценка колонизации корней и определение ростостимулирующего эффекта инокуляции сельскохозяйственных растений коммерческим штаммом Trichoderma asperellum .
Методика . Работу проводили в Институте биохимии и физиологии растений и микроорганизмов, ФИЦ Саратовский научный центр РАН (ИБФРМ РАН) с мая по август 2024 года. Использовали коммерческий штамм T. asperellum OPF-19 (ВКПМ F-1323) и семена рапса Br a ssica n a pus L. сорта Визит, сои Glycine max (L.) Merr. сорта Бара, кукурузы Zea mays L. (гибрид РНИИСХ-19), подсолнечника Helianthus annuus L. сорта Саратовский 20, пшеницы яровой Triticum aestivum L. сорта Саратовская 74.
Для инокуляции растений T. asperellum получали споры гриба, выращивая его на агаризованной среде BRM (23) в течение 5 сут. По окончании культивирования образовавшиеся споры смывали 5 % раствором Tween 20 (24), концентрировали центрифугированием, трижды промывая стерильной водопроводной водой.
Семена растений стерилизовали поверхностно гипохлоритом натрия, раскладывали на поверхность разбавленного (1:1) агара ГРМ и выдерживали в термостате (ВТ-120, «Laboratorni Pristroje», Чехия) при 29 ° С в течение 23 сут для контроля стерильности. Для пшеницы использовали глубокую стерилизацию семян диацидом (25). По окончанию эксперимента стерильность корней контролировали их инкубацией на чашках с агаризованной средой BRM.
Процесс колонизации корней грибом T. asperellum изучали, выращивая инокулированные и неинокулированные стерильные растения в агаризованной (0,4 %) минеральной среде Кнопа (26). Грибные споры вносили в остывшую, но еще жидкую среду до конечной концентрации 107 клеток/мл. После застывания на поверхность среды помещали стерильные проростки (27). Растения культивировали 7-10 сут в фитокомнате с контролируемыми условиями: температура — 23-25 °С, освещенность — 8000 лк, продолжительность светового периода — 14 ч, темнового — 10 ч. После этого растения извлекали из пробирок, корни отмывали стерильной водой. Для выявления гриба и определения его локализации на поверхность агаризованной среды BRM раскладывали отрезки опытных нативные и поверхностно стерилизованных этанолом и гипохлоритом корней (28), полученные из различных зон: роста, всасывания и проведения (боковых корней). Чашки с корнями инкубировали при 29 °С в течение 2 сут, затем отмечали участки корней, в которых выявлялся рост гриба. Рост гриба на нативных корнях при отсутствии роста на стерилизованных свидетельствовал об их поверхностной колонизации. Дополнительно эффективность колонизации определяли микроскопированием корней в проходящем свете (микроскоп Leica DM2500, «Leica Microsystems GmbH», Германия). Гифы и споры T. asperellum предварительно окрашивали трипановым синим (29).
Эффект инокуляции оценивали по длине побегов и корней растений, в случае стержневой корневой системы определяли длину главного корня, в случае мочковатой — их суммарную длину. Вычисляли средние значения длины корневой системы и побегов в пересчете на одно растение.
Для почвенных экспериментов использовали чернозем южный со следующими показателями: N-NH 4 — 44,6 (30), N-NO 3 — 9,9 мг/кг (ГОСТ 26488-85. М., 1985), P 2 O 5 — 50,5 мг/кг (ГОСТ Р 54650—2011. М., 2011), С общ — 2,54 % (ГОСТ 26213-91. М., 1991), рН 6,78 (ГОСТ 26483-85. М., 1985). В вегетационные сосуды помещали по 1 кг почвы, увлажняли ее до 50 % от полной влагоемкости, что составляло 170 мл/кг почвы. В каждый сосуд высевали по 20 семян исследуемых растений, после всходов оставляли по 10 проростков. Через 14 сут после посева растений в горшки вносили споры гриба в количестве 107 клеток/г почвы (вместе с водой для полива). Повторную инокуляцию проводили через 1 мес после первой. Продолжительность вегетационного опыта составляла 2 мес. Растения культивировали в фитокомнате с контролируемыми условиями: температура — 23-25 ° С, освещенность — 8000 лк, продолжительность светового периода — 14 ч, темнового — 10 ч. По окончании эксперимента растения извлекали из сосудов, корни отделяли от побегов и тщательно отмывали. Биомассу корней и побегов высушивали до постоянной массы, вычисляли средние значения надземной и подземной биомассы в пересчете на одно растение. Результаты выражали в % от неинокулированного контроля.
Результаты измерений растительной биомассы обрабатывали статистически, вычисляя средние значения ( M) и стандартные отклонения (±SD). Достоверность различий между инокулированными и неинокулированными вариантами оценивали с помощью непараметрического критерия Манна-Уитни при р < 0,05. Статистический анализ проводили в программе Microsoft Office Excel 2016 и Statistica 13.0 («StatSoft, Inc.», США).
Результаты . Культивирование растений в стерильных условиях in vitro в агаризованной среде в присутствии T. asperellum и без инокуляции позволило охарактеризовать колонизацию корней грибом. Инкубация различных участков корня на поверхности агаризованной питательной среды позволила установить локализацию гриба в разных зонах корня (рис. 1). Использование поверхностно стерилизованных корней позволило судить о том, проникают ли гифы внутрь или колонизируют лишь поверхность (рис. 1). Микроскопирование корней дало возможность выявить наличие вегетативного мицелия, образование конидий гриба и подтвердить эффективность инокуляции (рис. 2).
На корнях всех контрольных неинокулированных растений не наблюдалось роста гриба, также рост отсутствовал после поверхностной стерилизации (см. рис. 1), что свидетельствовало о поверхностной колонизации корней грибом T. asperellum .
Вокруг всех участков корней инокулированных растений рапса, размещенных на агаризованной среде, наблюдался рост мицелия (см. рис. 1, А). При микроскопировании было выявлено, что поверхность корней по всей длине покрывали грибные гифы, также встречались конидии (см. рис. 2, А).
Б

A

Рис. 1. Корни рапса Br a ssica n a pus L. сорта Визит (A) , сои Glycine max (L.) Merr. сорта Бара (Б) , кукурузы Zea mays L. (гибрид РНИИСХ-19) (В) , подсолнечника Helianthus annuus L. сорта Саратовский 20 (Г) и пшеницы яровой Triticum aestivum L. сорта Саратовская 74 (Д) , колонизированные грибом Trichoderma asperel-lum OPF-19 (ВКПМ F-1323) без стерилизации (слева) и после поверхностной стерилизации
д
(справа) (ИБФРМ РАН, 2024 год).
Вокруг корней сои обнаруживался рост мицелия, более обильный в зоне боковых корней (см. рис. 1, Б). Микроскопия выявляла вегетативный мицелий и конидии на поверхности корня (см. рис. 2, Б). На поверхности корней кукурузы, инокулированных грибом, его рост наблюдался преимущественно в зоне проведения (см. рис. 1, В), микроскопия также показала, что мицелий и конидии гриба T. asperellum располагались на поверхности корня, не проникая внутрь (см. рис. 2, В).
Инокулированные растения подсолнечника развивались очень плохо, корни были короткими, выделить отдельные зоны не удалось, при этом вокруг корня наблюдался обильный рост мицелия (см. рис. 1, Г). Микроскопия позволила выявить вегетативный мицелий и конидии на всей поверхности корня (см. рис. 2, Г). При раздавливании было видно, что в тканях внутри корня мицелий отсутствует.
Поверхность корней пшеницы T. asperellum колонизировала преимущественно в зоне всасывания и проведения (см. рис. 1, Д). На поверхности инокулированных корней обнаруживались вегетативный мицелий и конидии (см. рис. 2, Д).
Определение длины корней и побегов проростков, выращенных в стерильных условиях в агаризованной среде, позволило оценить влияние T. asperellum на рост растений при их инокуляции (рис. 3).
Согласно полученным данным, T. asperellum не оказывал влияния на развитие побегов злаков — пшеницы и кукурузы, тогда как длина корней у этих растений уменьшалась почти на 20 и 50 %, соответственно. Присутствие триходермы оказало сходное негативное влияние на рапс и сою: наблюдалось уменьшение длины побегов и корней почти на 24 и 45 %, соответственно. Наиболее выраженный негативный эффект инокуляции грибом наблюдался по отношению к подсолнечнику: в 4 раза уменьшалась 136
длина побегов и почти в 7 раз — корней.
А Б

в г

Рис. 2. Вегетативный мицелий и конидии Trich-oderma asperellum OPF-19 (ВКПМ F-1323) на поверхности корней рапса Br a ssica n a pus L. сорта Визит (А) , сои Glycine max (L.) Merr. сорта Бара (Б) , кукурузы Zea mays L. (гибрид РНИИСХ-19) (В) , подсолнечника Helianthus annuus L. сорта Саратовский 20 (Г) и пшеницы яровой Triticum aestivum L. сорта Саратовская 74 (Д) (окраска трипановым синим, увеличение 40 х, микроскоп Leica DM2500, «Leica Microsystems GmbH», Германия) ( ИБФРМ РАН, 2024 год).
д

Для оценки влияния иноку ляции на развитие растений в несте рильных условиях, приближенных к реальным, был проведен почвенный эксперимент, в котором оценивали прирост надземной и подземной растительной биомассы по сравнению с неинокулированным контролем. Полученные результаты заметно отличались от описанных выше для стерильных проростков (рис. 4).
Инокуляция T. asperellum оказывала максимальный положительный эффект на рапс: надземная биомасса увеличивалась на 26 %, подземная — на 39 %. У растений сои T. asperellum отчетливо стимулировала развитие корневой системы (почти на 40 %), тогда как надземная часть практически не отличалась от контроля. В меньшей степени инокуляция влияла на образование надземной и подземной частей подсолнечника (увеличение на 14-17 %). В отношении злаковых, пшеницы и кукурузы обнаруживался выраженный негативный эффект от инокуляции. Накопление надземной биомассы снижалось на 11 и 24 %, а подземной биомассы — на 32 и 64 % соответственно для кукурузы и пшеницы (см. рис. 4).
120-1

Рис. 3. Длина побегов (а) и корней (б) у проростков рапса Br a ssica n a pus L. сорта Визит (1) , подсолнечника Helianthus annuus L. сорта Саратовский 20 (2) , сои Glycine max (L.) Merr. сорта Бара (3) , кукурузы Zea mays L. (гибрид РНИИСХ-19) (4) и пшеницы яровой Triticum aestivum L. сорта Саратовская 74 (5) при инокуляции Trichoderma asperellum OPF-19 (ВКПМ F-1323) в условиях in vitro по сравнению с контролем (без инокуляции) ( n = 10, M± SEM; ИБФРМ РАН, 2024 год).
* Отличия от контроля статистически значимы при р < 0,05.

Рис. 4. Накопление биомассы растений рапса Br a ssica n a pus L. сорта Визит (1) , подсолнечника Helianthus annuus L. сорта Саратовский 20 (2) , сои Glycine max (L.) Merr. сорта Бара (3) , кукурузы Zea mays L. (гибрид РНИИСХ-19) (4) и пшеницы яровой Triticum aestivum L. сорта Саратовская 74 (5) при инокуляции Trichoderma asperellum OPF-19 (ВКПМ F-1323) в условиях почвенного эксперимента по сравнению с контролем (без инокуляции) ( n = 3, M± SEM; ИБФРМ РАН, 2024 год).
* Отличия от контроля статистически значимы при р < 0,05.
Разнонаправленное действие инокуляции растений триходермой в зависимости от условий описывалось и ранее (21, 31). Угнетение роста растений грибом в условиях стерильного выращивания in vitro, на наш взгляд, может быть связано с агрессивной колонизацией корней в условиях монокультуры и, как следствие, ухудшением питательного режима растения (2). При колонизации более глубоких слоев корня, включая сосудистые пучки, триходерма может себя вести не как симбиотический, а как условно-патогенный микроорганизм (31). Не исключается также продукция аскомицетом вторичных метаболитов, негативно влияющих на рост макропартнера, что может регулироваться условиями окружающей среды и растением (21, 32).
Грибы рода Trichoderma способны продуцировать соединения, обладающие гербицидными свойствами. Примерами таких веществ могут быть глиотоксин (эпидитиодикетопиперазин) и виридин (производное стирола) (33). Не на все растения эти соединения оказывают одинаковое токсическое действие. Так, глиотоксин и виридин ингибировали всхожесть семян и образование корней гречихи при концентрации 1 ppm в чашке Петри (32), но не влияли на всхожесть семян и рост красного клевера и пшеницы, что свидетельствовало о различной устойчивости растений к грибным токсинам. В проведенном нами исследовании также была показана разница в колонизации корней разных растительных видов: наиболее успешно гриб заселял корни рапса, а наименее активно — корни сои (см. рис. 1). На примере подсолнечника отчетливо было заметно фитотоксическое действие исследованного штамма T. asperellum в стерильных условиях in vitro (см. рис. 1, 3), тогда как при культивировании в почве отмечался ростостимулирующий эффект инокулянта, выражавшийся в увеличении накопления как надземной, так и подземной биомассы (см. рис. 4).
Известно, что синтезируемые грибом вторичные метаболиты обладают неодинаковой устойчивостью в разных условиях окружающей среды, вследствие чего на результат может непосредственно повлиять выбор системы, что и наблюдалось в нашем исследовании. Влияние среды на направление воздействия инокулянта подтверждается результатами других работ (21). Так, в условиях почвенного эксперимента штамм T. asperellum LU1370 снижал массу проростков арабидопсиса, не вызывая их гибели, тогда как при тестировании на агаризованной среде в чашках оказывал положительный эффект на рост растений (21). Такие результаты могут свидетельствовать о том, что в разных условиях образуются разные метаболиты либо меняется соотношение накапливающихся специфических соединений. Однако для окончательного вывода необходимы более глубокие дополнительные исследования.
Таким образом, в проведенных экспериментах мы наблюдали противоположные эффекты инокуляции растений грибом Trichoderma asperellum OPF-19 (ВКПМ F-1323) в зависимости от условий культивирования — стерильных in vitro и не стерильных почвенных. Так, в стерильных условиях гриб выраженно ингибировал рост подсолнечника, тогда как в почвенном эксперименте, напротив, стимулировал его. В отношении злаков, наоборот, в условиях in vitro гриб оказывал минимальный негативный эффект на развитие растений, тогда как при культивировании в почве заметно угнетал их. Развитие и корней, и побегов рапса и сои ингибировалось в стерильных условиях, в почве наблюдался обратный эффект. Выявленные различия во влиянии на растения свидетельствуют о необходимости тщательного подбора условий тестирования штаммов, перспективных для стимуляции роста сельскохозяйственных культур.
Институт биохимии и физиологии растений и микроорганизмов — обособленное структурное подразделение ФГБУН ФИЦ Саратовский научный центр РАН ,


